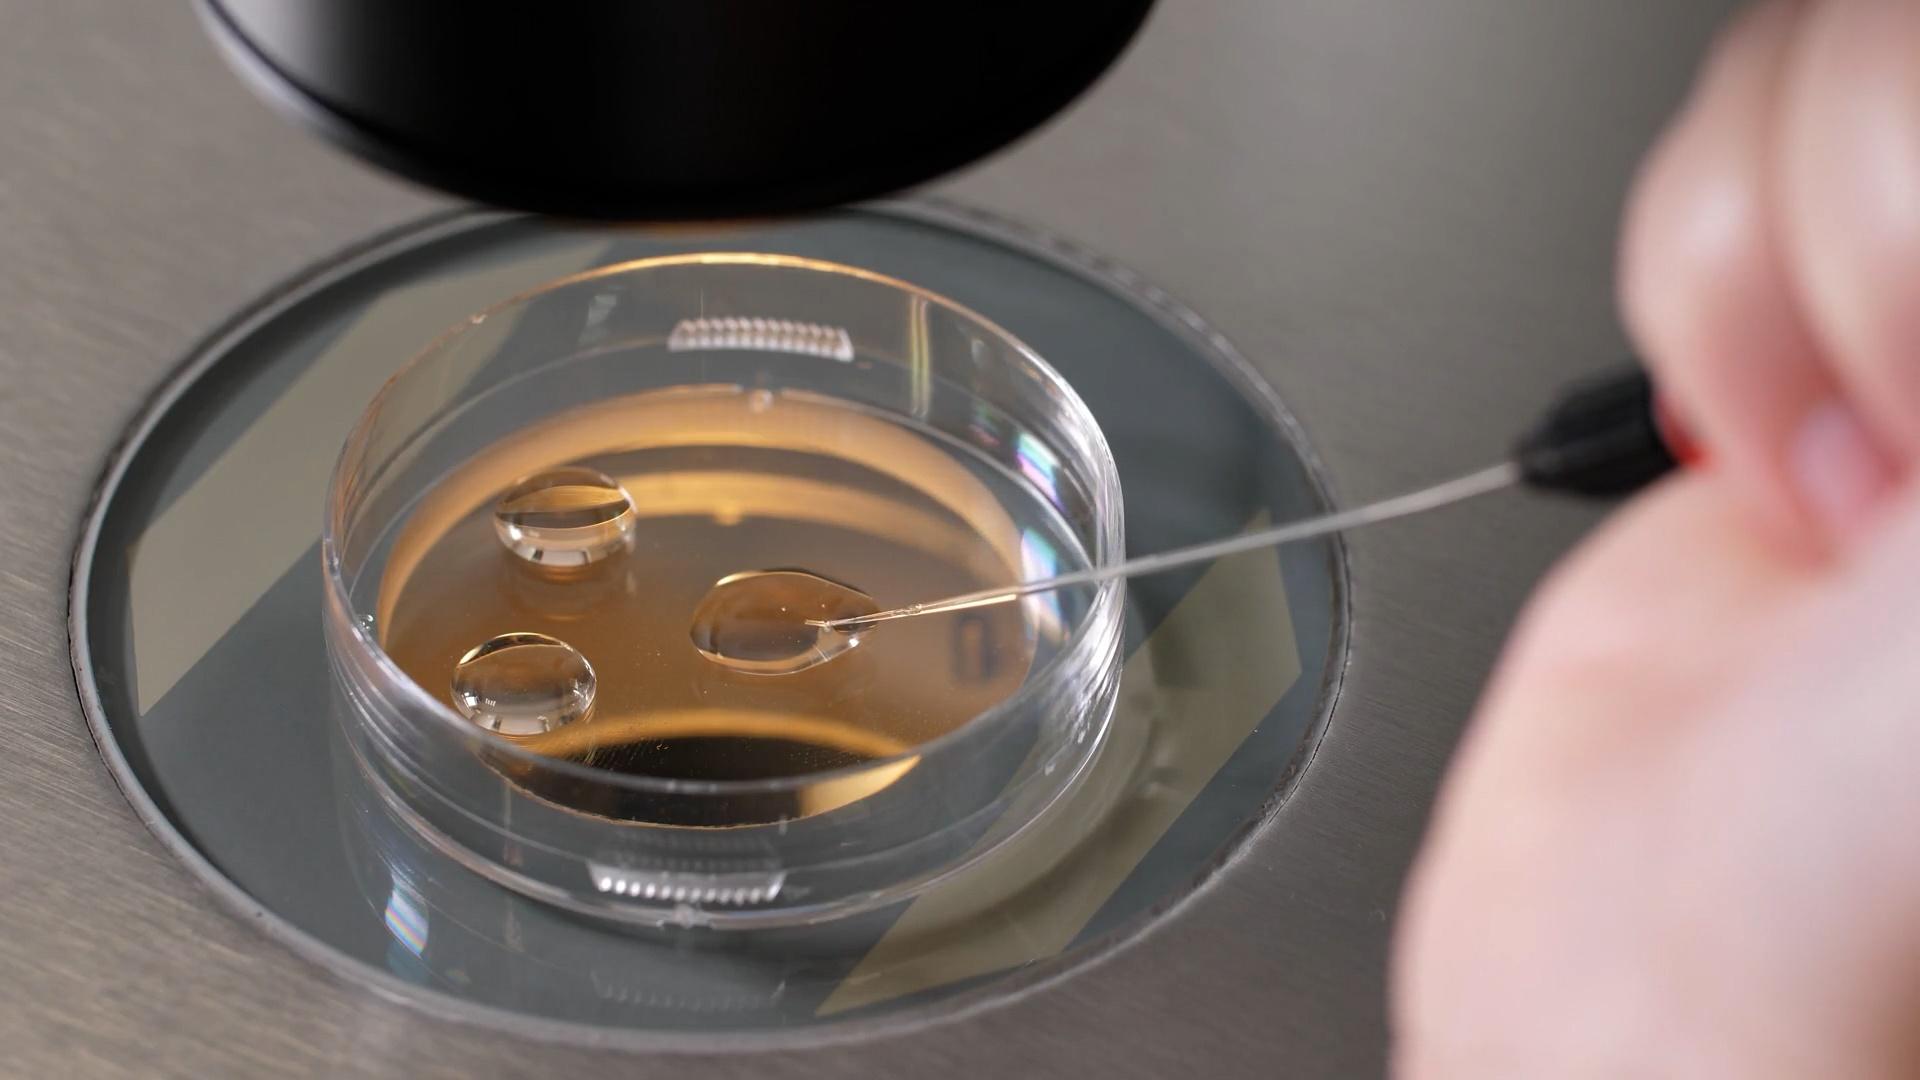

- News and Public Affairs
- TV-PG
How the SCOTUS Has Changed: Interview with Joan Biskupic
With women in the forefront of politics and on the cutting edge of national agendas, To the Contrary with Bonnie Erbe continues to provide an important, timely forum for diverse women to discuss national and international issues and policies. It presents news and views that are rarely, if ever, available elsewhere on television.
How the SCOTUS Has Changed: Interview with Joan Biskupic
Season 32 Episode 3204 | 26m 46s | CC
This week we take a deep dive into the changing face of the US Supreme Court. Joan Biskupic, a full-time legal analyst for CNN, talks to us about her new book, Nine Black Robes, and about the history and present of the SCOTUS.
Subscribe to Our Newsletters
Get trusted Colorado stories, programs, and events from Rocky Mountain PBS straight to your inbox.